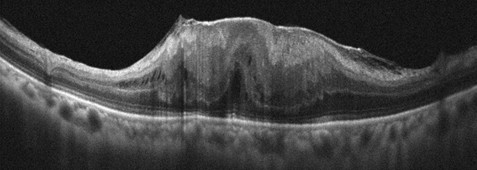

臺北榮總眼科部視網膜科主任 林泰祺暨病理檢驗部主治醫師 王蕾琪
黃斑部皺褶是常見的眼底疾病,在視網膜黃斑部表面形成一層薄膜,導致視力模糊、扭曲變形,甚至影響生活品質。
眼底鏡檢查黃斑部皺褶圖片1.png) (圖一)眼底鏡檢查黃斑部皺褶
(圖一)眼底鏡檢查黃斑部皺褶
根據統計,黃斑部皺褶的好發率大概為總人口的5.3%到18.5%。而早期的黃斑部皺褶通常沒有明顯的症狀,臨床上需透過眼底鏡檢查(圖一)或是同調共軛光掃描儀(圖二)來診斷。
共軛光掃描儀檢查可檢查出不同型態的黃斑部皺褶分期。隨著疾病的進展,黃斑部也產生結構的破壞。圖片2.png) (圖二)共軛光掃描儀檢查可檢查出不同型態的黃斑部皺褶分期。隨著疾病的進展,黃斑部也產生結構的破壞。
(圖二)共軛光掃描儀檢查可檢查出不同型態的黃斑部皺褶分期。隨著疾病的進展,黃斑部也產生結構的破壞。
隨著疾病的進展,則可能造成視覺功能受損,影響生活品質。過去,手術治療多僅限於視力嚴重受影響的患者,大約有70%至80%的患者在成功移除黃斑部皺褶後能恢復視力,但仍有部分患者即使手術順利,視力改善仍相當有限。
組織病理學檢驗部分,研究發現,黃斑皺褶主要由三種細胞組成:膠質細胞、玻璃體細胞以及纖維細胞。其中,膠質細胞占比最高,且會隨疾病進展而不斷增生。研究結果顯示,膠質細胞密度愈高的黃斑皺褶患者手術後視力恢復就愈差。相較之下,玻璃體細胞與纖維細胞的影響力較小。換言之,膠質細胞是造成視網膜結構受損與視覺惡化的關鍵角色。
膠質細胞的異常增生(圖三)會導致黃斑部增厚與結構扭曲,進一步造成病人視線模糊、影像變形。更重要的是,這種細胞變化可能早於共軛光掃描儀影像上可見的結構變化,因此光靠影像檢查,往往無法及時判斷疾病惡化的速度。
組織病理學檢驗發現膠質細胞的異常增生圖片3.png)
(圖三)組織病理學檢驗發現膠質細胞的異常增生
66歲馮先生,左眼有視網膜剝離的病史,2019年手術後恢復良好,術後五個月回診追蹤發現,左眼視力下降至只有0.08,檢查發現黃斑部皺褶(圖四),手術移除後視力回復至0.9,但仍感到看東西時有輕微的扭曲變形。
(圖四)共軛光掃描儀檢查發現左眼黃斑部皺褶已導致黃斑部結構嚴重變形。
(圖四)共軛光掃描儀檢查發現左眼黃斑部皺褶已導致黃斑部結構嚴重變形。
2022年馮先生左眼術後三年,偶然發現右眼看東西時也產生輕微的扭曲變形,就醫檢查右眼視力略為下降至0.8,也發現黃斑部皺褶(圖五)。因症狀輕微,雖在傳統的認定上是不需要立即接受手術的,林泰祺主任仍建議及早手術,有助於保留黃斑部功能並提升術後視力恢復的可能性。馮先生接受建議,術後右眼視力回復至1.0,看東西扭曲變形的情形完全獲得改善。
共軛光掃描儀檢查顯示右眼黃斑部皺褶為前期的變化。圖片5.jpg) (圖五)共軛光掃描儀檢查顯示右眼黃斑部皺褶為前期的變化。
(圖五)共軛光掃描儀檢查顯示右眼黃斑部皺褶為前期的變化。
黃斑皺褶過去常被認為是「良性、進展緩慢」的疾病,通常只有在患者視力嚴重受損時才會建議動手術。不過,隨著顯微手術與影像技術的進步,手術風險與併發症已大幅降低,患者術後恢復速度也更快。
最後呼籲民眾,千萬不要忽視「看東西扭曲變形」的症狀,即使症狀輕微也應該及早就醫、及早治療。並提醒臨床醫師在判斷手術時機時,應該導入「早期介入」的觀點,除了考慮視力與共軛光掃描影像的分期外,更應理解疾病的細胞層面變化,醫病齊心協力,才能守護黃斑部這個最重要的視覺中樞,維持良好的生活品質。

